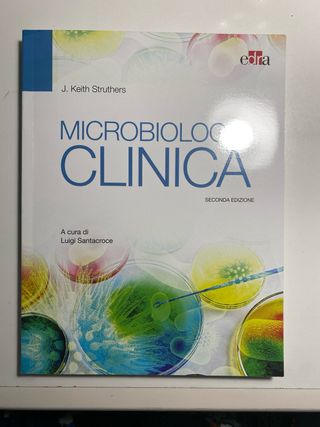
Libro universitario di microbiologia

Libri, musica e film di seconda mano Bari
Suggerimenti per te
Novità
Poster A3 Lupin
Poster in formato A3 - Stampa di alta qualità. - Dimensioni: 29.7 x 42 cm.
Diego per te. Da un grande maestro di stile e b...
Libro in buonissime condizioni, pari al nuovo
Titina De Filippo CD Canzone Napoletana
CD Titina De Filippo interpretata dalla canzone napoletana d'autore. - Artisti partecipanti: Eugenio Bennato, Nino Buonocore, Tony Esposito, Pietra Montecorvino, Mariella Nava, Riccardo Pazzaglia, Lina Sastri e altri. - Etichetta: RCS Libri / Fabbri.
Porta plettri a forma di amplificatore. Púas
Originale porta plettri a forma di mini amplificatore per chitarra. Perfetto per tenere in ordine i tuoi plettri. - Design unico a forma di amplificatore. - Colore nero con dettagli dorati e griglia nera. - Può contenere diversi plettri.

Fumetti topilino
100 fumetti misti, Topolino
Forget-me-not. Life is strange
Fumetto completo “Life is Strange: Forget-Me-Not” edizione italiana Panini Comics ✨ Sequel a fumetti del videogioco pluripremiato “Life is Strange: True Colors” con Alex Chen e Steph Gingrich 📖 Contiene: numeri 1-4 della serie completa + contenuti bonus dietro le quinte ✍️ Autori: Zoe Thorogood (vincitrice Russ Manning Award 2023), Claudia Leonardi, Andrea Izzo 🎨 Condizioni: Nuovo 📦 Spedizione accurata e protetta 112 pagine - peso 520 g
2 Microfonos replicas de SM57 + Accessorios
Set di due microfoni dinamici replica dei leggendari Shure SM57 più: - 1 cavo xlr - 2 adattatori per microfono e 2 borselli porta microfono
Poster vintage Cioè 1990
Poster originale della rivista Cioè del 1990. 40x53 cm - Raffigura due cani con cappelli e birra. - Scritta AMICIZIA È... BERE INSIEME!.
Poster Vintage James Dean Brooklyn Nights
Poster vintage Brooklyn Nights con James Dean. 40x53 cm Edizioni Cioè 1990 - Immagine iconica di James Dean. - Ambientazione notturna con ponte e skyline. - Titolo Brooklyn Nights in basso.
Bastard Manga 1-21 Completa Prima Edizione Granata
Bastard!! manga di Kazushi Hagiwara 1-21 completa prima edizione Editore: Granata Press Z Comix Lingua: italiano In ottime condizioni
Elvis Presley G.I. Blues RCA Italiana LP
Disco LP G.I. Blues di Elvis Presley. - Etichetta: RCA Italiana - Genere: Colonna sonora - Codice: LPM-2256 vendo vinile rca italiana elvis presley g.i.blues 1 stampa copertina un po usurata disco in buone condizioni con buon ascolto
Quadro dipinto a mano
Quadro dipinto a mano con acrilico e smalto su legno. Impreziosito da un zircone incastrato sull'occhio. Misure 50x50
Poster vintage edizioni Cioè 1990
Poster Madonna del 1990 in allegati con il giornalino Cioè Misure 55x80 cm
Poster A3 Martini Donna
Poster formato A3 con un'elegante stampa. - Raffigurazione di una donna con cappello rosso e abito bianco. - Logo Martini in alto.

Libro Filotto Juventus L'Airone
Libro Filotto Juventus Di Matteo Recanatesi Da Conte ad Allegri, da Del Piero a Cristiano Ronaldo, viaggio nel ciclo più lungo della storia bianconera. Collaborazione ai testi di Marco Terrenato Prefazioni di Michel Platini e Mario Sconcerti L'airone 2019 Appare come in foto Per qualsiasi informazione non esitate a contattarmi 😊

Libro Cristiano Ronaldo Il sogno di sempre! CR7
Libro Cristiano Ronaldo Il sogno di sempre! Di Alberto Castellano CR7, tutta la sua storia L'airone 2018 Appare come in foto Per qualsiasi informazione non esitate a contattarmi 😊
Poster A3 Lupin Fujiko
Poster in formato A3 - Stampa di alta qualità. - Dimensioni: A3 (29.7 x 42 cm).
Poster Campari A3
Poster in stile Art Déco con soggetto Campari. - Stampa di alta qualità. - Formato A3. - Applicata su pannello rigido in legno con gancetto
Poster A3 Martini Art
Poster in formato A3 - Stampa di alta qualità su carta fotografica 250 grammi - ❗Supporto rigido in legno con gancetto disponibile su richiesta
Vinile 7 Opalite Taylor Swift
Vinile singolo Opalite di Taylor Swift✨ - Formato 7 pollici - Edizione speciale con vinile colorato opalescente✅ -Lo spedisco quando mi sarà arrivato📦 Prima di acquistarlo scrivimi
Poster A3 Vogue donna
Poster formato A3 con un'illustrazione ispirata a Vogue. - Stampa di alta qualità. - Cartoncino fotografico 250 grammi. ❗ Disponibile con supporto in legno con gancetto: chiedi info ❗
Quadro Poster A3 Campari Art Deco Donna
Poster in stile Art Deco con soggetto Campari. - Stampa di alta qualità formato A3 applicata su pannello rigido in legno con gancetto -
Georgie - Cristina D'Avena 45 Giri 1984
Sigla originale del Cartone Animato "Georgie" 1984, sul lato B la versione strumentale completa di cori originali. Ottimo pezzo da avere in raccolta. Il supporto suona con leggero fruscio tipico dei dischi molto usati e senza salti. La cover è rigenerata, pari ad originale. Vendo come doppio da collezione privata. Spedito con imballo fatto con cura per evitare rotture o danni all'oggetto.
Bettino Craxi Un passo avanti libro + cartolina
Libro "Un passo avanti": Il celebre volume che ripercorre le tesi e la visione politica di Craxi. Un documento fondamentale per comprendere l'evoluzione del Partito Socialista Italiano. Cartolina d'epoca: Rara cartolina ufficiale del partito, con grafica originale dell'epoca. Perfettamente conservata, ideale per essere incorniciata. Spilla Ufficiale del Partito: Spilla originale con il simbolo storico (Garofano/Sole), un pezzo autentico di merchandising politico degli anni d'oro del PSI.
DVD Kill Bill volume 1 e volume 2
vendo DVD originali prima visione panorama di Kill Bill volume 1 e volume 2 scritto e diretto da Quentin Tarantino Ottime condizioni, perfetto, originale 10/10 Spedizione rapida ed accurata
WWE 2004 Cofanetto box 6 DVD
Cofanetto con 6 DVD di eventi WWE del 2004. - Royal Rumble 2004 - No Way Out 2004 - The Great American Bash 2004 - Vengeance 2004 - SummerSlam 2004 - Unforgiven 2004 Ottime condizioni, perfetto, originale Scatola, custodie e DVD 10/10 Spedizione rapida ed accurata
Bundle 3 Microfónos dinámicos cardioides y superc.
Set di 3 microfoni con cavo xlr. - Due microfoni replica del mitico Sm57 della Shure - Un microfono replica del leggendario e945 della Sennheiser perfetto per cantanti - Due supporti per microfono. - Due Custodie - Un cavo XLR incluso - Microfoni fatti in PRC.
Microfono modello e945
Microfono dinamico replica di un Sennheiser e945. Nuovo. - Cavo incluso.
VHS Diana Una Ragazza a Corte
VHS documentario su Lady Diana, Una Ragazza a Corte. Contiene immagini inedite in video. - Titolo: Diana, Una Ragazza a Corte - Temi trattati: Le Nozze, L'Amore, Le Delusioni
Il Boch: Dizionario Francese-Italiano Italiano-...
Dizionario molto usato e con evidenti segni di scritte
Manga DRAGON BALL STAR COMICS AKIRA TORIYAMA
Manga di DRAGON BALL NEW EDITION STAR COMICS di AKIRA TORIYAMA. Vendo Intera Collezione di Manga di 42 pezzi originali e perfetti , in ottime condizioni, messi sotto vuoto. Spedizione rapida e accurata
Poster A3 Martini Donna
Poster formato A3 con un design ispirato al brand Martini. - Raffigurazione stilizzata di una donna con cappello rosso. - Dettagli in rilievo dorati e neri. - Logo Martini presente in alto a sinistra.
Queen
Vendo libro dei queen come in foto
Madonna
Vendo libro di madonna come in foto
Almanacco
Vendo almanacco mondiali come in foto
Poster A3 Martini Donna Lampada
Poster formato A3 con un'elegante illustrazione Martini. - Raffigurazione di una donna con abito rosso e cappello, accanto a un lampione. - Sfondo nero con dettagli dorati e rossi. - Stampa di alta qualità.
Quadro Poster A3 Betty Boop Martini
Poster formato A3 - Stampa di alta qualità applicata su pannello rigido in legno con gancetto. ❗Solo Poster A3, 9 euro " " A4, 6.5 euro ❗❗ Sconto set ❗❗
Madonna - Miles Away Picture Disc Vinile 45 Giri
Disco in vinile picture disc Miles Away di Madonna. - Lato A: Miles Away (4:48), Miles Away (Thin White Duke Remix) (6:09) - Lato B: Miles Away (Rebirth Remix) (7:30), Miles Away (Johnny Vicious Club Mix) (7:28) - Edizione speciale con grafica tour stamp.
Quadro Poster A3 Martini Donna
Poster formato A3 con un'elegante stampa di alta qualità applicata su pannello rigido in legno con gancetto. Pronto da appendere
Quadro Poster A3 Campari L'Aperitivo dal 1860
Poster in formato A3 con un'iconica pubblicità Campari. - Stampa di alta qualità applicata su pannello rigido in legno con gancetto. Pronto da appendere
Poster A3 Jack Daniel's Western
Poster in formato A3 con un'illustrazione a tema western. - Raffigura una bottiglia di Jack Daniel's e un bicchiere. - Presenta una donna con cappello da cowboy e pistole. - Ambientazione saloon con tramonto.
Poster A3 Jack Daniel's
Poster formato A3 con un design ispirato a Jack Daniel's. - Stampa di alta qualità. - Motivo grafico con bottiglia e bicchiere di whiskey.
Poster A3 Martini Donna Gialla
Poster formato A3 con un'illustrazione ispirata al mondo Martini. - Stampa di alta qualità. - Raffigura una donna con abito giallo e cappello rosso. - Elementi grafici dinamici e colorati.
Poster A3 Red Passion
Poster formato A3 con un'illustrazione artistica. - Raffigura labbra rosse, un bicchiere di vino rosso e scarpe con tacco. - Presenta la scritta red passion e CAMPARI.
Zildjian A Custom Crash 19
IL CRASH per eccellenza, suono brillante, esplosivo, tagliente e ma mai fastidioso, grazie alla grande misura da 19. Piatto in perfette condizioni, quei segni che ho fotografato che possono sembrare tagli sono semplici segni di ossidazione, che non inficiano minimamente nello spettacolare suono. No Keyhole, no crepe, no flea bites, circonferenza perfetta senza curvature
Lotto CD Musica Classica, Opera, Pop Rock
Lotto misto di CD musicali con generi vari. - Include Il Trovatore di Verdi con Herbert von Karajan. - Presente Anna O di Anna Oxa. - Altri titoli visibili includono Le pagine più belle e No mi tisdire. - Copertine e CD visibili nelle foto. Misti
Stock cartone cd musica new age
Come da foto

Cd musicali new age
Come da foto

Cd musicali nuova era lotto
Totale prezzo intero lotto cd musica
Lotto 17 CD New Age Art, Oasi, Inside, Energy, Res
Lotto composto da 10 CD musicali di genere New Age. - Art - Oasi - Inside - Energy - Respiro - Diamonds - Floating - Solaria - Fantasy - Il Volo
Zildjian Low Volume Cymbals Pack 14 16 18
Zildjian Low Volume pack CON LE MISURE PIU GRANDI composto da: - Hi Hat da 14 pollici - Crash da 16 pollici - Ride/Crash da 18 pollici Spedisco nel loro cartone CONDIZIONI OTTIME, NO KEYHOLE, NO CREPE.
Vocabolario tascabile vintage Italiano-Spagnolo
Piccolo vocabolario tascabile vintage 1970, italiano/spagnolo. Ideale per chi ama il vintage e le lingue. - Copertina in plastica color legno. - Titolo Italiano Spagnolo stampato. - Editrice Capitol, Bologna. - A cura di M. Bonelli e del Prof. Sante David Università di Bologna. - Usato ma in ottimo stato, solo le pagine sono un po' ingiallite, piacevole caratteristica del tempo passato.
Zildjian K Istanbul Old Stamp Hi Hat 12 pollici
Zildjian K Istanbul Old Stamp 12 pollici Hi Hat 12 pollici Suono meraviglioso, molto scuro e fat, a dispetto della misura! Il peso dei piatti è molto simile, il top 522 gr mentre il bottom 571, quaindi collocabile del peso thin. Presenta un piccolo buchetto, come da foto, che non inficia minimamente il suono ed è fermo lì, e cè anche il keyhole un pò deformato del top, ma rientra tutto nella normalità dato che parliamo di un piatto di quasi 100 anni. Patina naturale, non è mai stato pulito in nessuna maniera Piatto di nicchia e molto ricercato dai collezionisti, specialmente per le sue misure e peso
LP Jam Block Rosso
LP Jam block red, un pò scolorito e la meccanica un po arrugginita (come in foto) ma perfettamente funzionante.

Hercules DJControl Glow Console DJ
Console DJ Hercules DJControl Glow, trasparente. - Jog wheel. - Fader. - Pulsanti. - Manopole.

Canta Tu USB Deluxe Karaoke DVD
Set di DVD e CD per cantare con Canta Tu. Include Canta Tu USB Deluxe e altri titoli. - Canta Tu USB Deluxe (DVD) - I Grandi Successi del Karaoke (CD 29) - I Giganti del Pop Volume 2 (CD 16) - New Hits Italia Vol. 2 (CD 22) - Top Hits Volume 2 (CD 18) - Hits Now (CD 27)
TUTTA LA VERITA, NIENT'ALTRO CHE UNA BUGIA
Romanzo
La porta proibita
Tiziano terzani
Libro concorso
Concorso agenzia dogane e Monopoli 2025 Teoria e test
Lotto Fumetti Diabolik
1. 56 fumetti Diabolik - lotto Condizioni varie, alcuni pari al nuovo (esempio nella seconda foto), altri copertine rovinate (numeri più vecchi) 2. Diabolik - serie “gli anni della gloria” n. 31 - Grilletto facile / La maschera che uccide n. 32 - Il fantasma del passato / La banda del pugno di ferro (piccolo difetto sul bordo laterale superiore come visibile in foto) n. 33 - Imprendibile cassaforte / Agguato al rifugio 3. Diabolik - serie “gli anni della ferocia” - n.22
To Love ru " Venus "
Descrizione dell'oggetto: In vendita due splendidi e ricercatissimi artbook dedicati alla celebre serie To Love-Ru Darkness, realizzati dal leggendario maestro Kentaro Yabuki. Questi volumi sono un must-have assoluto per ogni fan della saga e per gli amanti del disegno di alta qualità. Il lotto include: Artbook "Venus": Una raccolta di illustrazioni spettacolari a colori, con i personaggi principali in vesti eleganti e sensuali. Caratteristiche del prodotto: Autore: Kentaro Yabuki Lingua: Giapponese (testi minimi, focus totale sulle illustrazioni) Condizioni: Ottime/Pari al nuovo. Gli artbook sono stati conservati con estrema cura,
To Love ru
Sei un fan sfegatato di To LOVE-Ru? Non lasciarti sfuggire questo splendido artbook originale giapponese! "Love Color" è la celebrazione definitiva del tratto inconfondibile del maestro Kentaro Yabuki, un must-have assoluto per ogni collezione che si rispetti. ✨ Perché acquistarlo? Contenuti Esclusivi: Centinaia di illustrazioni a colori vibranti che ripercorrono la storia della serie. Qualità Premium: Carta di alta qualità e stampa impeccabile per esaltare ogni dettaglio del design dei personaggi. Condizioni Ottime: Il volume è conservato con cura (come visibile in foto), completo di sovraccoperta originale e fascetta pubblicitaria
Cablaggio Meazzi Vintage per Chitarra
Componenti originali per cablaggio vintage Meazzi, ideali per chitarre. - Due potenziometri. - Un selettore. - Condensatori. - Fili di collegamento.
Ponte per chitarra Crucianelli Meazzi Welson
Ponte per chitarra vintage, compatibile con marchi come Crucianelli, Meazzi, Welson, Galanti e Ariston. Un pezzo di ricambio o per personalizzare il tuo strumento. - Materiale metallico cromato. - Design a 6 sellette. - Regolazioni individuali per ogni corda.
Mr. Bean's Holiday DVD Rowan Atkinson
Vendo il divertentissimo film "Mr. Bean's Holiday" in formato DVD, con protagonista l'inimitabile Rowan Atkinson. In questa avventura, Mr. Bean vince una vacanza nel sud della Francia, scatenando una serie di catastrofi esilaranti tra Cannes e la Costa Azzurra. Contenuti Extra: Oltre 45 minuti di scene eliminate e "Mr. Bean a Cannes" Lingue Audio: Italiano, Inglese, Tedesco, Spagnolo (Surround 5.1) Sottotitoli: Disponibili in numerose lingue (tra cui Italiano, Inglese, Francese, ecc.) Condizioni: Buone. La custodia presenta alcuni adesivi e segni tipici dell'edizione noleggio(come visibile in foto). Il disco è in buone condizioni
Libro universitario di microbiologia
Libro universitario di microbiologia mai usato di J. Keith Struthers tradotto dal prof.re di Microbiologia dell’Univerista degli Studi di Bari Aldo Moro Luigi Santacroce
Libri x bambini
3 Libri per bambini nuovi con 10 pagine ciascuno
Travis Scott Utopia Vinile
Vinile dell'album Utopia di Travis Scott. - Genere: International Rap & Hip Hop
Lotto Image anni 1995 - 1996 Youngblood Spawn
Vendo splendido lotto di 6 albi della mitica era Image Comics anni '90, edizione italiana a cura di Star Comics. Gli albi sono un tuffo nel passato per ogni appassionato del periodo "Extreme". Il lotto include: • Extreme Youngblood n. 10 (Agosto 1995) • Extreme Youngblood n. 12 (Ottobre 1995) • Image n. 26 (Dicembre 1995) • Spawn & Savage Dragon n. 26 (Maggio 1996) • Image n. 31 (Maggio 1996) • Image n. 32 (Giugno 1996) Condizioni: Gli albi sono in buone condizioni, conservati con cura. Segni del tempo minimi come da foto.
Naruto - Collezione completa
72 volumi manga della saga di “Naruto” di Masashi Kishimoto. Ogni volume ha il relativo segnalibro colorato in cartoncino. Edizione “Panini Comics”
Star Wars: Darth Vader - Panini Comics 2017
In vendita il raro albo promozionale Darth Vader edito da Panini Comics per il Free Comic Book Day 2017. L'albo segna l'inizio della leggendaria run di Charles Soule e Giuseppe Camuncoli, ambientata subito dopo Episodio III. Scopri come il Signore Oscuro ottiene il suo cristallo Kyber rosso e consolida il legame con Palpatine. • Editore: Panini Comics (Edizione Fuori Commercio) • Anno: 2017 • Condizioni: Ottime, come da foto (no pieghe o strappi). • Contenuto: Prologo esclusivo della serie "Signore Oscuro dei Sith". Un pezzo da collezione imperdibile per ogni fan di Star Wars! #StarWars #DarthVader #PaniniComics #FCBD #Collezionismo
Dylan Dog il giorno del giudizio
Splendido volume "Dylan Dog - Il giorno del giudizio" edito da Mondadori nella collana Oscar Bestsellers (maggio 2002). Testi di Tiziano Sclavi. Il libro raccoglie diverse storie classiche dell'Indagatore dell'Incubo. Condizioni: Ottime/Molto buone. Pagine bianche, costina perfetta. Piccola piega d'uso sull'angolo della copertina (vedi foto). Spedizione rapida e imballo protetto.
Batteria Elettronica Medion con Pedali
Batteria elettronica Medion portatile, ideale per esercitarsi o suonare. - Pad sensibili al tocco. - Design compatto e arrotolabile. - Include due pedali. - Cavo di alimentazione incluso.
Image Star Comics 1994: Annata Completa GEN-DIC
Occasione per collezionisti: vendo l’annata completa 1994 della serie Image (Star Comics). Il lotto comprende i 12 volumi usciti da gennaio a dicembre (numeri dal 3 al 14). Rivivi il mito dei supereroi anni '90 con le firme leggendarie di Jim Lee, Todd McFarlane, Marc Silvestri e Rob Liefeld. Il lotto include le storie di: • Spawn • WildC.A.T.s • Cyberforce • Youngblood • Stormwatch & Brigade Condizioni: Albi originali conservati con cura. Integri, completi e in ottimo stato vintage (vedi foto). Disponibile per spedizione sicura con imballaggio protettivo rigido.

Storia del diritto privato romano
Storia del diritto romano Ulrich Manthe
Lotto fumetti Fantastici Quattro n.205+206 Marvel
PER COLLEZIONISTI! 💥 Vendo coppia imperdibile di albi originali Marvel Italia (Panini Comics) del 2001, appartenenti allo storico ciclo "Il Ritorno degli Eroi". Il lotto include: ✅ F4 n. 205: Storia "Perduti nella Zona Negativa". ✅ F4 n. 206: Iconica cover dedicata alla Cosa. CONDIZIONI DA EDICOLA: Gli albi sono stati conservati con cura maniacale. Come visibile dalle foto: • Copertine lucidissime e colori vibranti. • Costine perfette, senza pieghe da lettura. • Interni bianchi e integri. • Quarte di copertina (pubblicità vintage) intonse. Prezzo per il lotto. Non vendo separatamente.
I SIMPSON (BART) N.19 + RADIOACTIVE MAN N.88
I SIMPSON (BART) N. 19 + RADIOACTIVE MAN N. 88 - Macchia Nera 1999 🍩 Lotto di due albi storici della rarissima prima serie italiana (pre-Panini). Un tuffo nell'epoca d'oro di Springfield! ✅ Il lotto include: 1. I Simpson n. 19 (1998): Cover iconica con Bart "Bad". 2. Radioactive Man n. 88 (1999): Numero speciale dedicato al supereroe di Bart e Milhouse. ✨ Condizioni: Ottime per albi di oltre 25 anni. Pagine integre, costine ben tenute e colori vividi. Piccoli segni del tempo come da foto (per collezionisti esigenti). • Editore: Macchia Nera / Bongo Comics • Formato: Spillato classico, lingua italiana.
Peanuts - Tutto Peanuts (Hachette) Vol. 1 e 2
Peanuts - Tutto Peanuts (Hachette) Vol. 1 e 2 - Come Nuovi 📚 Vendo i primi due volumi della prestigiosa collana Hachette che raccoglie l'opera integrale di Charles M. Schulz in ordine cronologico. Edizione curatissima con strisce quotidiane in B/N e tavole domenicali a colori. ✅ Dettagli: • Vol 1: Anni 1950-1951 (esordio assoluto) • Vol 2: Anno 1952 • Extra: Fascicolo "Guida all'opera" incluso ✨ Condizioni: Pari al nuovo. Copertine rigide perfette, pagine bianche e pulite, costine integre. Ideale per collezionisti. Dettagli tecnici: Copertina rigida, formato orizzontale, lingua italiana (ed. 2022).
Fender Telecaster Thinline Chitarra Elettrica
Progetto di liuteria modello Fender Telecaster Thinline. Leggero relic, suono eccellente. Coppia di Pickup Fender Pure Vintage '64 originali. Setup appena effettuato, intonazione perfetta. Viaggio per lavoro, è possibile concordare consegna a mano o spedizione assicurata.